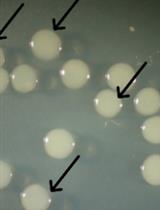
检测大肠杆菌中光激活的Cre介导的基因缺失效率

发布: 2018年04月20日第8卷第8期 DOI: 10.21769/BioProtoc.2812 浏览次数: 6969
评审: Valentine V TrotterAnonymous reviewer(s)
Abstract
Most of the cyanobacteria accumulate osmolytes including sucrose, glucosylglycerol, in their cells in response to salt stress. Here we describe a protocol of our laboratory for extraction and quantification of cyanobacterial intracellular sucrose and glucosylglycerol. We have confirmed this protocol was applicable to at least four kinds of cyanobacteria, filamentous cyanobacterium Anabaena sp. PCC 7120, unicellular cyanobacterium Synechocystis sp. PCC 6803, Synechococcus elongatus PCC 7942 and halotolerant unicellular cyanobacterium Synechococcus sp. PCC 7002.
Keywords: Osmolyte (渗透调节物质)Background
Osmolytes (or compatible solutes) are a group of low-molecular-weight organic solutes, and play important physiological roles on abiotic stress acclimation in microbes including cyanobacteria (Reed and Stewart, 1985; Klähn and Hagemann, 2011; Slama et al., 2015). For determination of intracellular osmolytes from cyanobacterial cells, several protocols have been established (Reed and Stewart, 1985; Hagemann et al., 1997; Motta et al., 2004; Du et al., 2013; Fa et al., 2015).
Among these methods, nuclear magnetic resonance (NMR) spectroscopy based method was the only one which could be directly applied on microbe cultures without any extraction procedure (Motta et al., 2004). However, this protocol has just been tested in cultures of Halomonas pantelleriensis and Sulfolobus solfataricus rather than in cyanobacterial cultures. For all other methods, 80% ethanol was used for extraction of osmolytes from cyanobacterial cells. After derivatization by some trimethyl-silyl reagents, the derivatives of osmolytes could be analyzed by gas chromatography (Reed and Stewart, 1985). Alternatively, the extracted osmolytes could be directly analyzed by high-performance liquid chromatography (HPLC) (Hagemann et al., 1997). Our lab has firstly reported our protocol for osmolyte determination by ion chromatography (IC) equipped with a carb-Pac®MA1 analytical column (Du et al., 2013). In this protocol (Du et al., 2013), the column was equilibrated with 600 mM NaOH with a flow rate of 0.4 ml/min, and the running time for one sample was 45 min. Later, the concentration of NaOH was increased to 800 mM, and the running time for each sample was shortened to 32 min (Song et al., 2016 and 2017). Recently, the PA10 analytical column was successfully used for osmolyte analysis by ion chromatography (Qiao et al., 2017), and the running time for one sample was further shortened to 10 min. It is worthy to note that our collaborator has established a novel method for osmolyte determination by combination of separation by capillary ion chromatography and detection by mass spectrometry (CIC-MS) (Fa et al., 2015). The NMR and CIC-MS based methods are suitable for determination of unknown osmolytes from cyanobacteria. Compared with these two methods as well as the GC and HPLC based methods, our IC based method has advantages on running time and accuracy which would be helpful for the high throughput osmolyte detection used in some cyanobacterial metabolic engineering reseaches.
Therefore, we detailedly present our recent IC-based protocol here for osmolyte determination in cyanobacterial cells.
Materials and Reagents
Equipment
Software
Procedure
文章信息
版权信息
© 2018 The Authors; exclusive licensee Bio-protocol LLC.
如何引用
Tan, X., Song, K., Qiao, C. and Lu, X. (2018). Determination of Intracellular Osmolytes in Cyanobacterial Cells. Bio-protocol 8(8): e2812. DOI: 10.21769/BioProtoc.2812.
分类
微生物学 > 微生物新陈代谢 > 糖类
微生物学 > 微生物生理学 > 适应
生物化学 > 糖类 > 多糖
您对这篇实验方法有问题吗?
在此处发布您的问题,我们将邀请本文作者来回答。同时,我们会将您的问题发布到Bio-protocol Exchange,以便寻求社区成员的帮助。
Share
Bluesky
X
Copy link